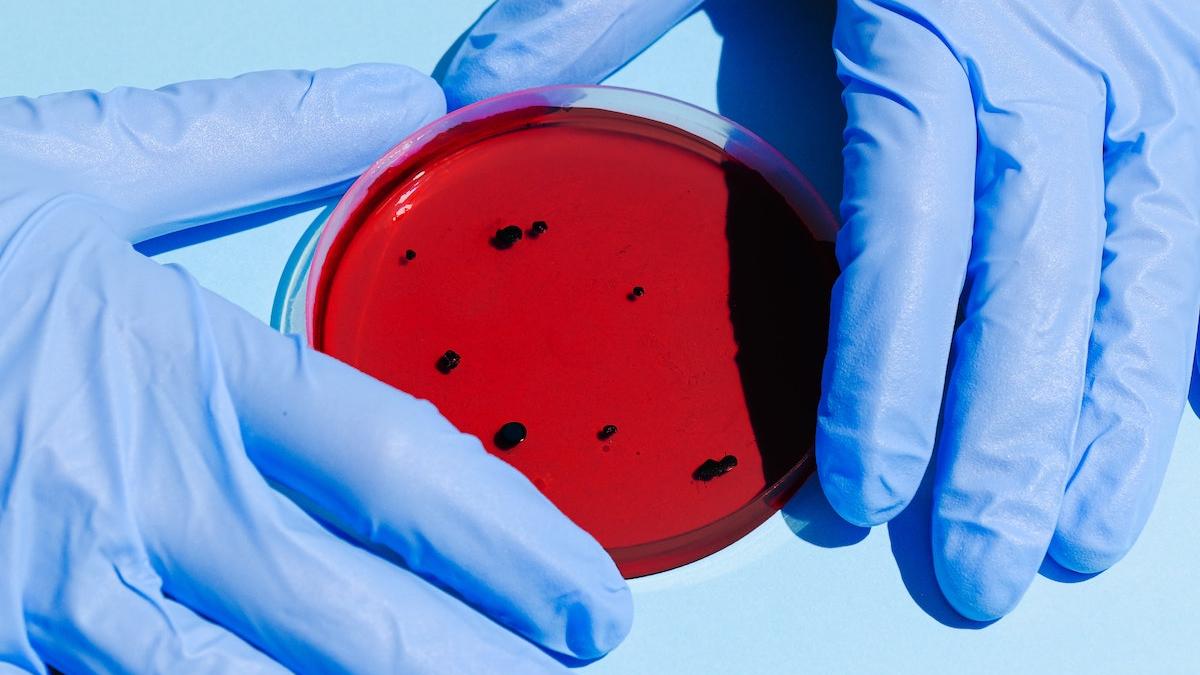
semnal de alarma oms super bacteriile ucid milioane oameni

Antena 3 CNN
›
Andreea Cigolea
Andreea Cigolea | Pagina 33

Andreea Cigolea este realizatorea emisiunii ”Sfat de Sănătate” și prezentator al jurnalelor de ştiri Antena 3 CNN.
Cu o vechime de peste 10 ani in presă, a început ca redactor în presa scrisă la Prosport, a continuat in online ca redactor la tabloidul Cancan și apoi în televiziune, la Kanal D și la Antena 3 CNN.
Cu o vechime de peste 10 ani in presă, a început ca redactor în presa scrisă la Prosport, a continuat in online ca redactor la tabloidul Cancan și apoi în televiziune, la Kanal D și la Antena 3 CNN.
Adresa de contact: [email protected]
Facebook - https://www.facebook.com/andreea.cigolea
Instagram - https://www.instagram.com/andreeacig/